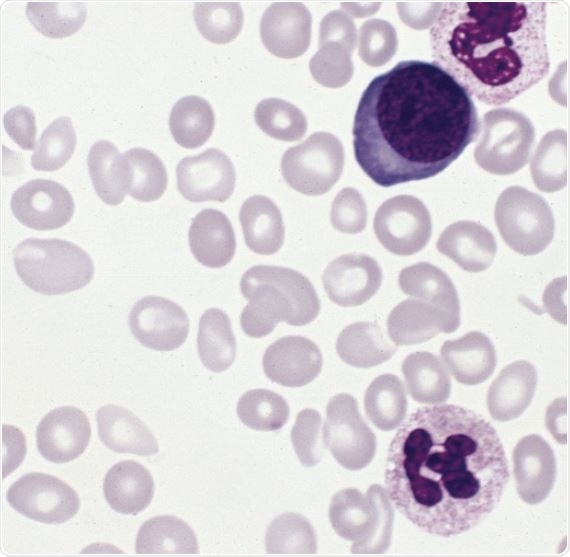
Blood smear from a patient with polycythemia vera

Polycythemia vera is a rare condition that affects the bone marrow, which is slow to progress and typically develops in later life. It is a condition characterized by the overproduction of red blood cells in the bone marrow.
A consequent thickening of the blood affects how efficiently the blood is able to travel through blood vessels and organs, and can present a number of symptoms due to its slower movement through the body.
Blood smear from a patient with polycythemia vera
Skip to
What Causes Polycythemia Vera?
Polycythemia vera develops in the bone marrow. Stem cells in the bone marrow produce the three main types of blood cells found in the blood: white blood cells, red blood cells, and platelets. In polycythemia vera, too many red blood cells are produced. This causes the blood to thicken and move more slowly around the body, putting those with the condition at a higher risk of blood clots and a range of other complications from slow blood flow.
Myeloproliferative neoplasms (MPNs) are genetic faults that can cause the overproduction of blood cells. MPNs in the gene JAK2 are usually the cause of polycythemia vera. As polycythemia vera is developed during a person’s normal lifespan due to this genetic fault, PV is rarely an inherited condition and cannot be passed on to children.
The bone marrow cells that are affected by mutations can sometimes develop into other types of blood cell, including platelets and white blood cells.
Overproduction of these types of blood cells can lead to other conditions similar to polycythemia vera, such as essential thrombocythemia (ET) or myelofibrosis.
ET is characterized by an overproduction of platelets, and myelofibrosis is a condition in which the bone marrow becomes scarred and its ability to produce cells is impaired.
PV can also sometimes progress to leukemia.
Incidence rates of PV are around twice as common in men as in women.
The Role of Gene JAK2 in Polycythemia Vera
Mutations in the gene JAK2 have been implicated in polycythemia vera incidence. The JAK2 gene regulates production rates of blood cells.
A particular mutation, V617F, is thought to make cells in hematopoietic (developmental) phases more sensitive to erythropoietin and thrombopoietin, two growth factors that are produced in the kidney, with thrombopoietin also being produced in the liver.
Growth factors are substances that send signals that result in the production of blood cells when counts are low. Erythropoietin stimulates the production of red blood cells, while thrombopoietin regulates platelet production.
Symptoms of Polycythemia Vera
People with polycythemia vera may not present any symptoms. However, the spleen may become enlarged by its efforts to break down the increased amount of red blood cells in the blood. Symptoms of an enlarged spleen include discomfort on the left abdominal side and feeling full quickly after eating.
The following symptoms have also been identified in polycythemia vera.
- Headaches
- Blurry vision
- Red skin on the face, hands, and feet
- Fatigue
- High blood pressure
- Dizziness
- Abdominal pain
- Periods of cognitive confusion
- Gout (inflammation of the joints)
- Itchy skin
- Abnormal bleeding and bruising.
Abnormal bleeding and bruising covers:
- Nosebleeds
- Bruising
- Abnormal vaginal bleeding in women
- Bleeding gums.
Diagnosis of Polycythemia Vera
There are a number of diagnostic tests available to confirm cases of polycythemia vera.
There is a specific blood test available that will check for mutations in the JAK2 gene. Additionally, blood tests can also be used to check:
- The levels of iron and vitamin B12 in the blood
- If the body is producing too much erythropoietin
- The oxygen saturation of the blood.
Tests to the bone marrow itself can also be used in diagnostic tests for polycythemia vera. A bone marrow biopsy can be taken from the back of the pelvis, which involves liquid marrow being extracted through a small needle (a bone marrow aspirate), followed by a bone marrow sample being taken from the bone itself.
Risk Factors for Polycythemia Vera
It is thought that PV is twice as common in men as it is in women. PV in children and young adults is rare, as the condition is most common in people over the age of 60.
Those with polycythemia vera are also at an increased risk of developing blood clots. Blood clots can be avoided by improving the blood flow around the body by safely increasing the heart rate through moderate exercise.
Developing polycythemia vera cannot be prevented through changes to lifestyle or screening programs, but the onset of symptoms and their related complications can be prevented through careful disease management and treatment.
Treatments for Polycythemia Vera
Treatments for polycythemia vera generally aim to reduce red blood cell counts down to normal levels by inhibiting the production of red blood cells.
Venesection is considered the fastest way to reduce red blood cell counts. Venesections may be carried out if a patient is at particular risk of blood clots, or they are presenting symptoms that suggest the blood is abnormally thick.
A venesection is a procedure during which approximately half a litre of blood is removed from the body. It is similar to the procedure for donating blood, and takes around 15 minutes to complete.
The frequency of a patient’s venesection appointments will vary in PV. Initially, venesections may be necessary every week, with procedures taking place every six to 12 weeks once the patient’s PV is under control.
How I Treat Polycythemia Vera - Alessandro Vannucchi, MD
Chemotherapy medications can be used to treat PV. These drugs reduce red blood cell proliferation to reduce the blood count. In rare cases, radioactive phosphorus (32P) may be used to irradiate bone marrow and reduce blood cell proliferation.
Certain painkillers can be taken to reduce the risk of blood clots, which can cause serious complications. Maintaining a healthy lifestyle can also reduce the risk of developing blood clots, including reducing weight if a patient is overweight, and not smoking.
If symptoms do occur in PV, treatments for these symptoms (in the case of gout or irritated skin, for instance) may also be given. Certain medications can be used to prevent gout.
Stem cell or bone marrow transplants are other treatment options for PV in cases that are progressing to leukemia or myelofibrosis, however these treatments are not suitable for every patient.
Summary
A rare condition that typically affects patients at around the age of 60, polycythemia vera is often caused by a mutation in the JAK2 gene. Due to the increased amount of red blood cells, the blood becomes thicker and travels less efficiently around the body.
Polycythemia vera can sometimes be asymptomatic, but some patients do present a number of symptoms caused by the slower speed at which blood travels around the body. Typically, polycythemia vera does not affect a patient’s normal lifespan.
Further Reading
Last Updated: Jul 21, 2023